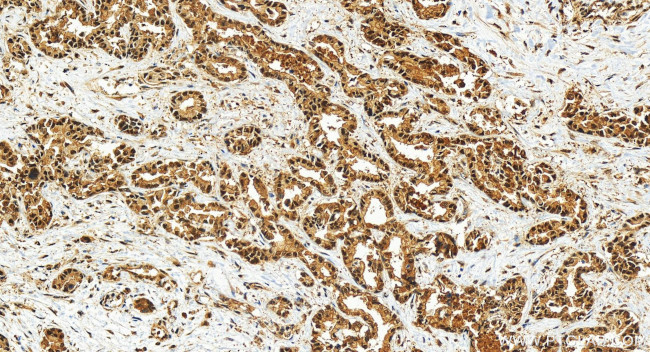
COPS3 Antibody in Immunohistochemistry (Paraffin) (IHC (P))

Search
Proteintech
COPS3 Polyclonal Antibody
{{$productOrderCtrl.translations['antibody.pdp.commerceCard.promotion.promotions']}}
{{$productOrderCtrl.translations['antibody.pdp.commerceCard.promotion.viewpromo']}}
{{$productOrderCtrl.translations['antibody.pdp.commerceCard.promotion.promocode']}}: {{promo.promoCode}} {{promo.promoTitle}} {{promo.promoDescription}}. {{$productOrderCtrl.translations['antibody.pdp.commerceCard.promotion.learnmore']}}
产品信息
30494-1-AP
种属反应
宿主/亚型
分类
类型
抗原
偶联物
形式
浓度
规格
纯化类型
保存液
内含物
保存条件
运输条件
产品详细信息
Immunogen sequence: NNPSELRNLV NKHSETFTRD NNMGLVKQCL SSLYKKNIQR LTKTFLTLSL QDMASRVQLS GPQEAEKYVL HMIEDGEIFA SINQKDGMVS FHDNPEKYNN PAMLHNIDQE MLKCIELDER LKAMDQEITV NPQFVQKSMG SQEDDSGNKP SSYS
靶标信息
The protein encoded by this gene possesses kinase activity that phosphorylates regulators involved in signal transduction. It phosphorylates I kappa-Balpha, p105, and c-Jun. It acts as a docking site for complex-mediated phosphorylation. The gene is located within the Smith-Magenis syndrome region on chromosome 17.
仅用于科研。不用于诊断过程。未经明确授权不得转售。
篇参考文献 (0)
生物信息学
蛋白别名: Arabidopsis COP9 subunit homolog; COP9 (constitutive photomorphogenic) homolog, subunit 3; COP9 (constitutive photomorphogenic), subunit 3; COP9 complex S3; COP9 complex subunit 3; COP9 constitutive photomorphogenic homolog subunit 3; COP9 signalosome complex subunit 3; COPS 3; JAB1-containing signalosome subunit 3; SGN3; signalosome subunit 3; unnamed protein product
基因别名: COPS3; CSN3; SGN3
UniProt ID: (Human) Q9UNS2, (Mouse) O88543, (Rat) Q68FW9
Entrez Gene ID: (Human) 8533, (Mouse) 26572, (Rat) 287367